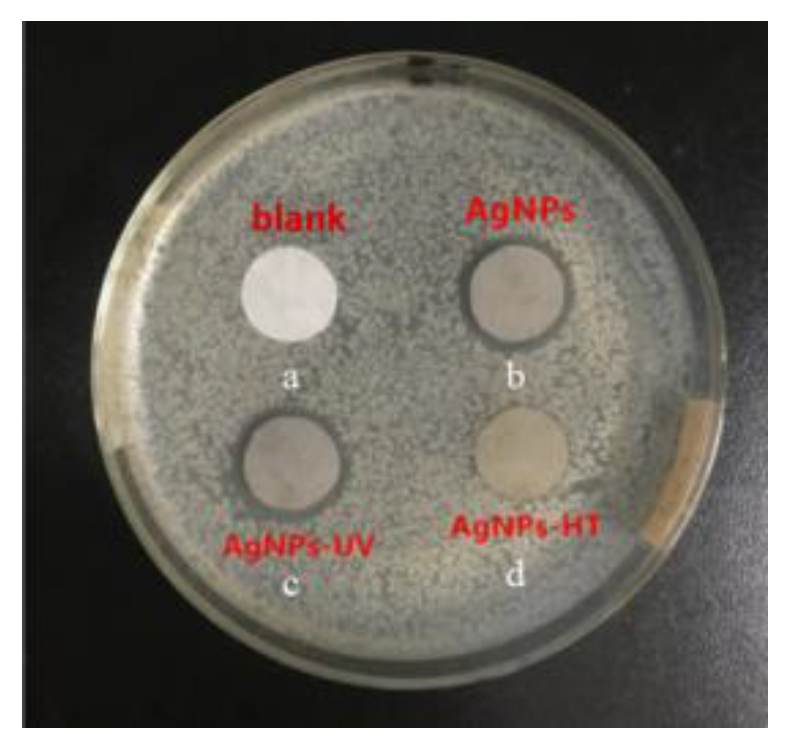
Polymers 15 03045 g003
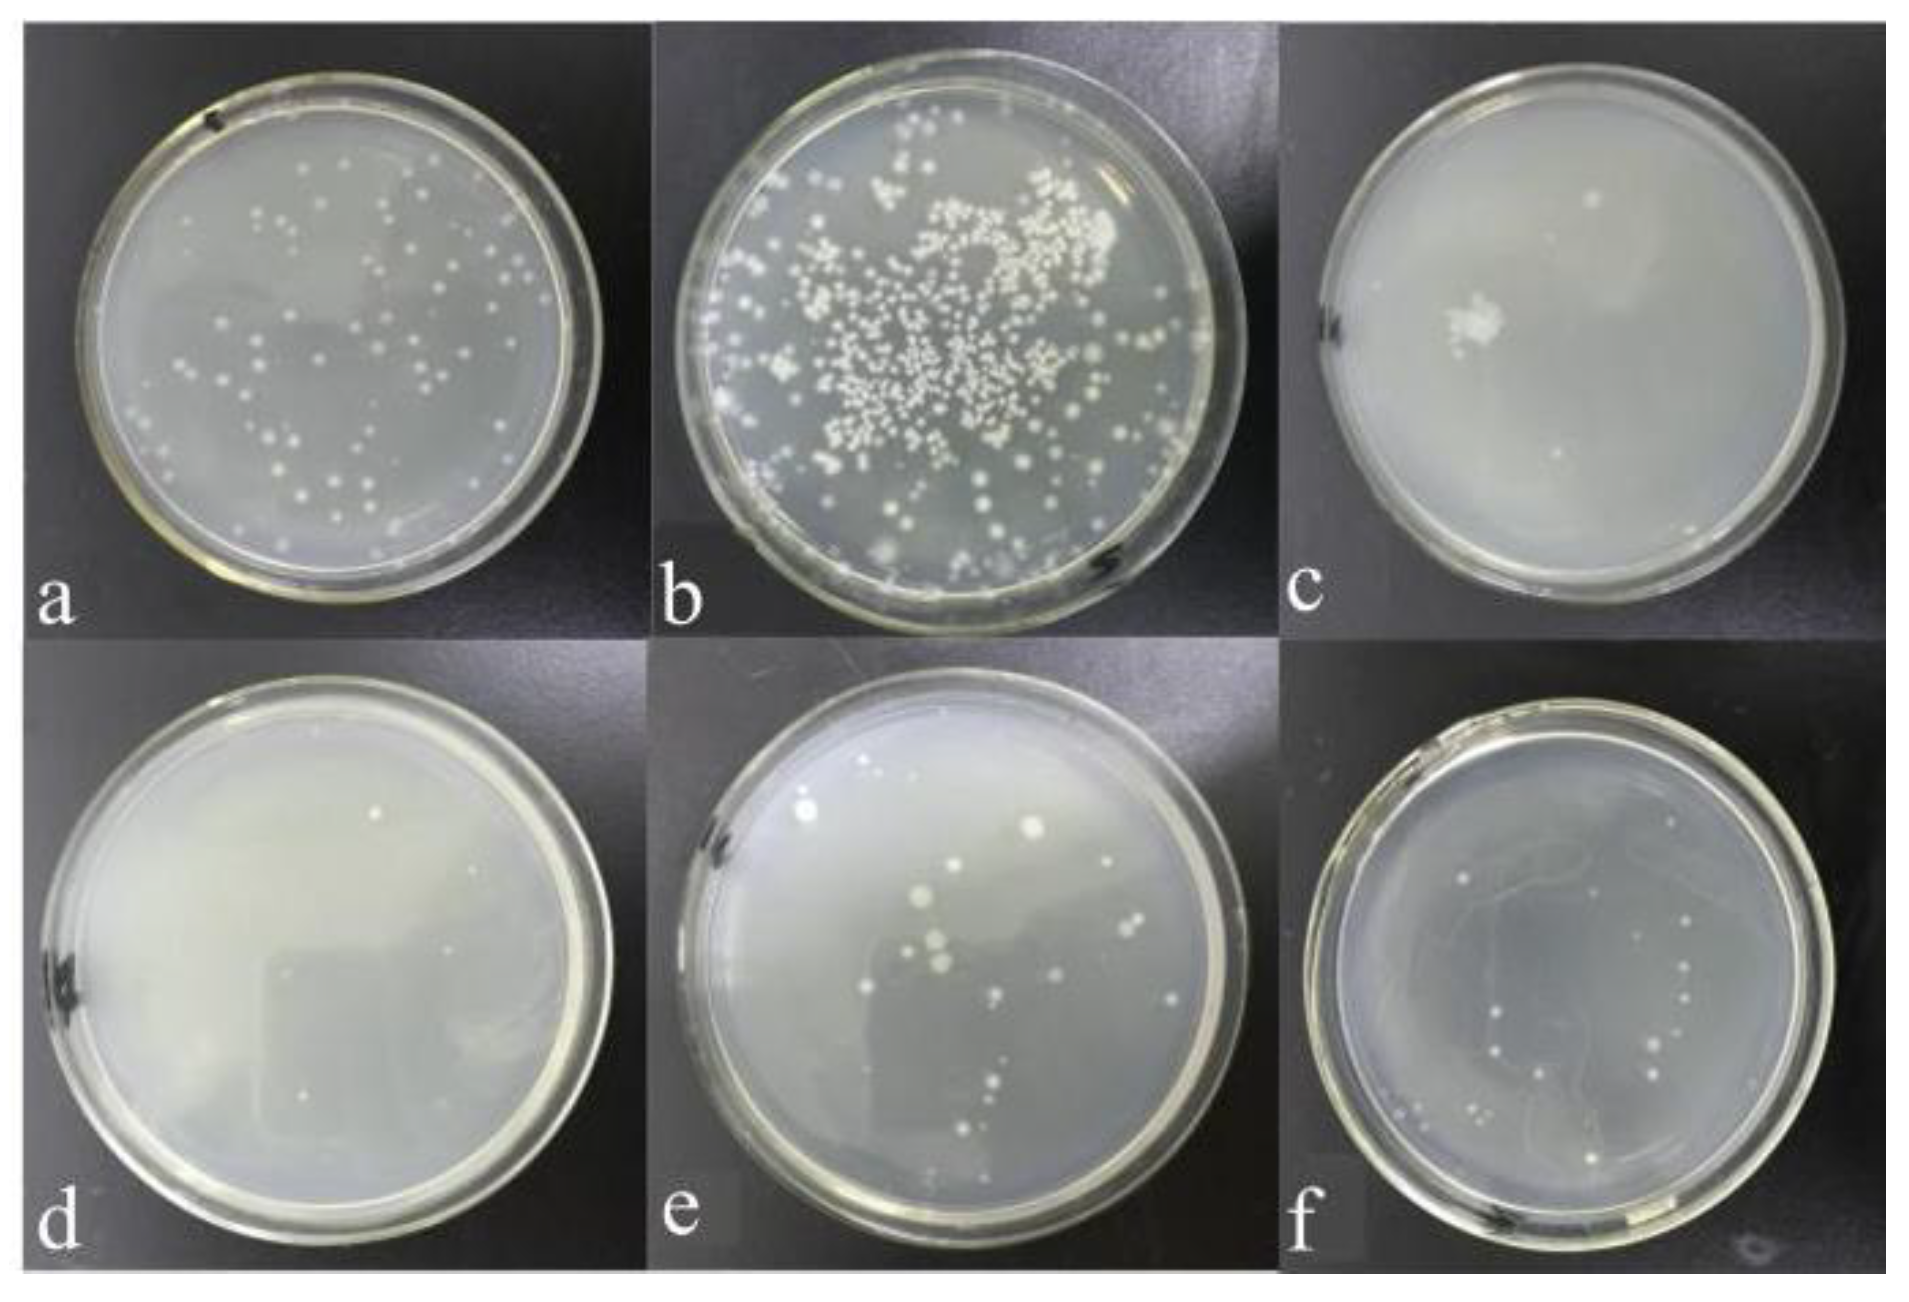
Polymers 15 03045 g005

Antioxidation Effect of Graphene Oxide on Silver Nanoparticles and Its Use in Antibacterial Applications
Abstract
1. Introduction
2. Materials and Methods
2.1. Materials
2.2. Preparation of AgNPs
2.3. Preparation of GO/AgNPs Composites
2.4. Preparation of PA/GO/AgNPs Nanocomposites
2.5. Antimicrobial Performance Test
2.6. Characterization
3. Results and Discussion
3.1. Characterization of AgNPs
3.2. Antibacterial Property
4. Conclusions
Author Contributions
Funding
Institutional Review Board Statement
Informed Consent Statement
Data Availability Statement
Acknowledgments
Conflicts of Interest
References
- Chanpiwat, P.; Sthiannopkao, S.; Widmer, K.; Himeno, S.; Miyataka, H.; Vu, N.; Tran, V.-V.; Pham, T.-T.-N. Assessment of metal and bacterial contamination in cultivated fish and impact on human health for residents living in the Mekong Delta. Chemosphere 2016, 163, 342–350. [Google Scholar] [CrossRef] [PubMed]
- Keshvardoostchokami, M.; Piri, F.; Jafarian, V.; Zamani, A. Fabrication and antibacterial properties of silver/graphite oxide/chitosan and silver/reduced graphene oxide/chitosan nanocomposites. J. Miner. 2020, 72, 4477–4485. [Google Scholar] [CrossRef]
- Majid, S.J.; Taha, M.R.; Uday, M.N.; Salim, A.; Faizah, A.A.; Jawaher, A.; Amal, A.A.; Zainab, J.T.; Ghassan, M.S. Inhibition of staphylococcus aureus α-hemolysin production using nanocurcumin capped Au@ZnO nanocomposite. Bioinorg. Chem. Appl. 2022, 2663812. [Google Scholar] [CrossRef]
- Wei, L.; Ma, J.; Zhang, W.; Pan, Z.; Ma, Z.; Kang, S.; Fan, Q. Enhanced antistatic and self-heatable wearable coating with self-tiered structure caused by amphiphilic MXene in waterborne polymer. Langmuir 2020, 36, 6580–6588. [Google Scholar] [CrossRef] [PubMed]
- Wei, L.; Zhang, W.; Ma, J.; Bai, S.-L.; Ren, Y.; Liu, C.; Simion, D.; Qin, J. π-π stacking interface design for improving the strength and electromagnetic interference shielding of ultrathin and flexible water-borne polymer/sulfonated graphene composites. Carbon 2019, 149, 679–692. [Google Scholar] [CrossRef]
- Aldosari, M.A.; Alsaud, K.B.B.; Othman, A.; Al-Hindawi, M.; Faisal, N.H.; Ahmed, R.; Michael, F.M.; Krishnan, M.R.; Asharaeh, E. Microwave irradiation synthesis and characterization of reduced-(graphene oxide-(polystyrene-polymethyl methacrylate))/silver nanoparticle nanocomposites and their anti-microbial activity. Polymers 2020, 12, 1155. [Google Scholar] [CrossRef]
- Xiu, Z.M.; Zhang, Q.B.; Puppala, H.L.; Colvin, V.L.; Alvarez, P.J.J. Negligible particle-specific antibacterial activity of silver nanoparticles. Nano Lett. 2012, 12, 4271–4275. [Google Scholar] [CrossRef]
- Morones, J.R.; Elechiguerra, J.L.; Camacho, A.; Holt, K.; Kouri, J.B.; Ramírez, J.T.; Yacaman, M.J. The bactericidal effect of silver nanoparticles. Nanotechnology 2005, 16, 2346–2353. [Google Scholar] [CrossRef]
- Sun, X.; Shi, J.; Zou, X.; Wang, C.; Yang, Y.; Zhang, H. Silver nanoparticles interact with the cell membrane and increase endothelial permeability by promoting VE-cadherin internalization. J. Hazard. Mater. 2016, 317, 570–578. [Google Scholar] [CrossRef]
- Sondi, I.; Salopek-Sondi, B. Silver nanoparticles as antimicrobial agent: A case study on E. coli as a model for Gram-negative bacteria. J. Colloid Interface Sci. 2004, 275, 177–182. [Google Scholar] [CrossRef]
- Kim, J.S.; Kuk, E.; Yu, K.N.; Kim, J.-H.; Park, S.J.; Lee, H.J.; Kim, S.H.; Park, Y.K.; Park, Y.H.; Hwang, C.-Y.; et al. Antimicrobial effects of silver nanoparticles. Nanomed. Nanotechnol. Biol. Med. 2007, 3, 95–101. [Google Scholar] [CrossRef] [PubMed]
- Wu, Z.; Tang, S.; Deng, W. Antibacterial chitosan composite films with food-inspired carbon spheres immobilized AgNPs. Food Chem. 2021, 363, 130342. [Google Scholar] [CrossRef] [PubMed]
- Singh, K.; Yadav, V.B.; Yadav, U.; Nath, G.; Srivastava, A.; Zamboni, P.; Kerkar, P.; Saxena, P.S.; Singh, A.V. Evaluation of biogenic nanosilver-acticoat for wound healing: A tri-modal in silico, in vitro and in vivo study. Colloids Surf. A Physicochem. Eng. Asp. 2023, 670, 131575. [Google Scholar] [CrossRef]
- Ma, J.; Pan, Z.; Zhang, W.; Fan, Q.; Li, W.; Liang, H. High sensitivity microchannel-structured collagen fiber-based sensor with antibacterial and hydrophobic properties. ACS Sustain. Chem. Eng. 2022, 10, 16814–16824. [Google Scholar] [CrossRef]
- Lansdown, A.B. A review of the use of silver in wound care: Facts and fallacies. Br. J. Nurs. 2004, 13 (Suppl. 1), S6–S19. [Google Scholar] [CrossRef]
- Reidy, B.; Haase, A.; Luch, A.; Dawson, K.A.; Lynch, I. Mechanisms of silver nanoparticle release, transformation and toxicity: A critical review of current knowledge and recommendations for future studies and applications. Materials 2013, 6, 2295–2350. [Google Scholar] [CrossRef]
- Han, W.; Wu, Z.; Li, Y.; Wang, Y. Graphene family nanomaterials (GFNs)-promising materials for antimicrobial coating and film: A review. Chem. Eng. J. 2019, 358, 1022–1037. [Google Scholar] [CrossRef]
- Wu, J.; Zhu, B.; Zhao, Y.; Shi, M.; He, X.; Xu, H.; Zhou, Q. One-step eco-friendly synthesis of Ag-reduced graphene oxide nanocomposites for antibiofilm application. J. Mater. Eng. Perform. 2020, 29, 255–2559. [Google Scholar] [CrossRef]
- Xiong, K.R.; Liang, Y.R.; Yang, Y.O.; Wu, D.; Fu, R. Nanohybrids of silver nanoparticles grown in-situ on a graphene oxide silver ion salt: Simple synthesis and their enhanced antibacterial activity. Carbon 2019, 158, 426–433. [Google Scholar]
- Jiang, L.; Zhu, Z.; Wen, Y.; Ye, S.; Su, C.; Zhang, R.; Shao, W. Facile construction of functionalized GO nanocomposites with enhanced antibacterial activity. Nanomaterials 2019, 9, 913. [Google Scholar] [CrossRef]
- Liang, Y.; Wang, M.; Zhang, Z.; Ren, G.; Liu, Y.; Wu, S.; Shen, J. Facile synthesis of ZnO QDs@GO-CS hydrogel for synergetic antibacterial applications and enhanced wound healing. Chem. Eng. J. 2019, 378, 122043. [Google Scholar] [CrossRef]
- Faria, A.F.; Martinez, D.S.T.; Meira, S.M.M.; Moraes, A.C.M.; Brandelli, A.; Filho, A.G.S.; Alves, O.L. Anti-adhesion and antibacterial activity of silver nanoparticles supported on graphene oxide sheets. Colloids Surf. B Biointerfaces 2014, 113, 115–124. [Google Scholar] [CrossRef] [PubMed]
- Liu, Y.; Wen, J.; Gao, Y.; Li, T.; Wang, H.; Yan, H.; Niu, B.; Guo, R. Antibacterial graphene oxide coatings on polymer substrate. Appl. Surf. Sci. 2018, 436, 624–630. [Google Scholar] [CrossRef]
- Chen, X.; Huang, X.; Zheng, C.; Liu, Y.; Xu, T.; Liu, J. Preparation of different sized nano-silver loaded on functionalized graphene oxide with highly effective antibacterial properties. J. Mater. Chem. B 2015, 3, 7020–7029. [Google Scholar] [CrossRef] [PubMed]
- Zhu, Z.; Su, M.; Ma, L.; Ma, L.; Liu, D.; Wang, Z. Preparation of graphene oxide-silver nanoparticle nanohybrids with highly antibacterial capability. Talanta 2013, 117, 449–455. [Google Scholar] [CrossRef]
- Zhu, K.; Tian, H.; Zheng, X.; Wang, L.; Wang, X. Triangular silver nanoparticles loaded on graphene oxide sheets as an antibacterial film. Mater. Lett. 2020, 275, 128162. [Google Scholar] [CrossRef]
- Tang, J.; Chen, Q.; Xu, L.; Zhang, S.; Feng, L.; Cheng, L.; Xu, H.; Liu, Z.; Peng, R. Graphene oxide-silver nanocomposite as a highly effective antibacterial agent with species-specific mechanisms. ACS Appl. Mater. Interfaces 2013, 5, 3867–3874. [Google Scholar] [CrossRef]
- Cobos, M.; De-La-Pinta, I.; Quindós, G.; Fernández, M.J.; Fernández, M.D. Synthesis, physical, mechanical and antibacterial properties of nanocomposites based on poly(vinyl alcohol)/graphene oxide-silver nanoparticles. Polymers 2020, 12, 723. [Google Scholar] [CrossRef]
- Menazea, A.A.; Ahmed, M.K. Synthesis and antibacterial activity of graphene oxide decorated by silver and copper oxide nanoparticles. J. Mol. Struct. 2020, 1218, 128536. [Google Scholar] [CrossRef]
- Cobos, M.; De-La-Pinta, I.; Quindós, G.; Fernández, M.J.; Fernández, M.D. One-step eco-friendly synthesized silver-graphene oxide/poly (vinyl alcohol) antibacterial nanocomposites. Carbon 2019, 150, 101–116. [Google Scholar] [CrossRef]
- Zhang, W.; Wei, L.; Ma, J.; Bai, S.-L. Exfoliation and defect control of graphene oxide for waterborne electromagnetic interference shielding coatings. Compos. A Appl. Sci. Manuf. 2020, 132, 105838. [Google Scholar] [CrossRef]
- Dixit, D.; Gangadharan, D.; Popat, K.M.; Reddy, C.R.K.; Trivedi, M.; Gadhavi, D.K. Synthesis, characterization and application of green seaweed mediated silver nanoparticles (AgNPs) as antibacterial agents for water disinfection. Water Sci. Technol. 2018, 78, 235–246. [Google Scholar] [CrossRef] [PubMed]
- Kummer, K.M.; Taylor, E.N.; Durmas, N.G.; Tarquinio, K.M.; Ercan, B.; Webster, T.J. Effects of different sterilization techniques and varying anodized TiO2 nanotube dimensions on bacteria growth. J. Biomed. Mater. Res. B Appl. Biomater. 2013, 101, 677–688. [Google Scholar] [CrossRef] [PubMed]
- An, Y.H.; Alvi, F.I.; Kang, Q.; Laberge, M.; Drews, M.J.; Zhang, J.; Matthews, M.A.; Arciola, C.R. Effects of sterilization on implant mechanical property and biocompatibility. Int. J. Artif. Organs 2005, 28, 1126–1137. [Google Scholar] [CrossRef] [PubMed]
- Tang, J.L.; Xi, T.F.; Liu, G.Q.; Xiong, L.; Wang, S.; Wang, J.; Liu, L.; Li, J.; Yuan, F. Influence of high temperature sterilization on dispersing of silver nanoparticles. Trans. Mater. Heat Treat. 2009, 30, 6–9. [Google Scholar]
- Hu, W.; Peng, C.; Luo, W.; Lv, M.; Li, X.; Li, D.; Huang, Q.; Fan, C. Graphene-based antibacterial paper. ACS Nano 2010, 4, 4317–4323. [Google Scholar] [CrossRef]
- Jang, J.; Choi, Y.; Tanaka, M.; Choi, J. Development of silver/graphene oxide nanocomposites for antibacterial and antibiofilm applications. J. Ind. Eng. Chem. 2020, 83, 46–52. [Google Scholar] [CrossRef]
- Jebaranjitham, J.N.; Mageshwari, C.; Saravanan, R.; Mu, N. Fabrication of amine functionalized graphene oxide-AgNPs nanocomposite with improved dispersibility for reduction of 4-nitrophenol. Compos. B Eng. 2019, 171, 302–309. [Google Scholar] [CrossRef]
- Chen, K.; Ray, D.; Peng, Y.; Hsu, Y.-C. Preparation of Cu-Ag core-shell particles with their anti-oxidation and antibacterial properties. Curr. Appl. Phys. 2013, 13, 1496–1501. [Google Scholar] [CrossRef]
- Krogman, K.C.; Lowery, J.L.; Zacharia, N.S.; Rutledge, G.C.; Hammond, P.T. Spraying asymmetry into functional membranes layer-by-layer. Nat. Mater. 2009, 8, 512–518. [Google Scholar] [CrossRef]

Disclaimer/Publisher’s Note: The statements, opinions and data contained in all publications are solely those of the individual author(s) and contributor(s) and not of MDPI and/or the editor(s). MDPI and/or the editor(s) disclaim responsibility for any injury to people or property resulting from any ideas, methods, instructions or products referred to in the content. |
© 2023 by the authors. Licensee MDPI, Basel, Switzerland. This article is an open access article distributed under the terms and conditions of the Creative Commons Attribution (CC BY) license (https://creativecommons.org/licenses/by/4.0/).
Share and Cite
Jin, H.; Cai, M.; Deng, F. Antioxidation Effect of Graphene Oxide on Silver Nanoparticles and Its Use in Antibacterial Applications. Polymers 2023, 15, 3045. https://doi.org/10.3390/polym15143045
Jin H, Cai M, Deng F. Antioxidation Effect of Graphene Oxide on Silver Nanoparticles and Its Use in Antibacterial Applications. Polymers. 2023; 15(14):3045. https://doi.org/10.3390/polym15143045
Chicago/Turabian StyleJin, Hua, Mengyao Cai, and Fuquan Deng. 2023. "Antioxidation Effect of Graphene Oxide on Silver Nanoparticles and Its Use in Antibacterial Applications" Polymers 15, no. 14: 3045. https://doi.org/10.3390/polym15143045
APA StyleJin, H., Cai, M., & Deng, F. (2023). Antioxidation Effect of Graphene Oxide on Silver Nanoparticles and Its Use in Antibacterial Applications. Polymers, 15(14), 3045. https://doi.org/10.3390/polym15143045




